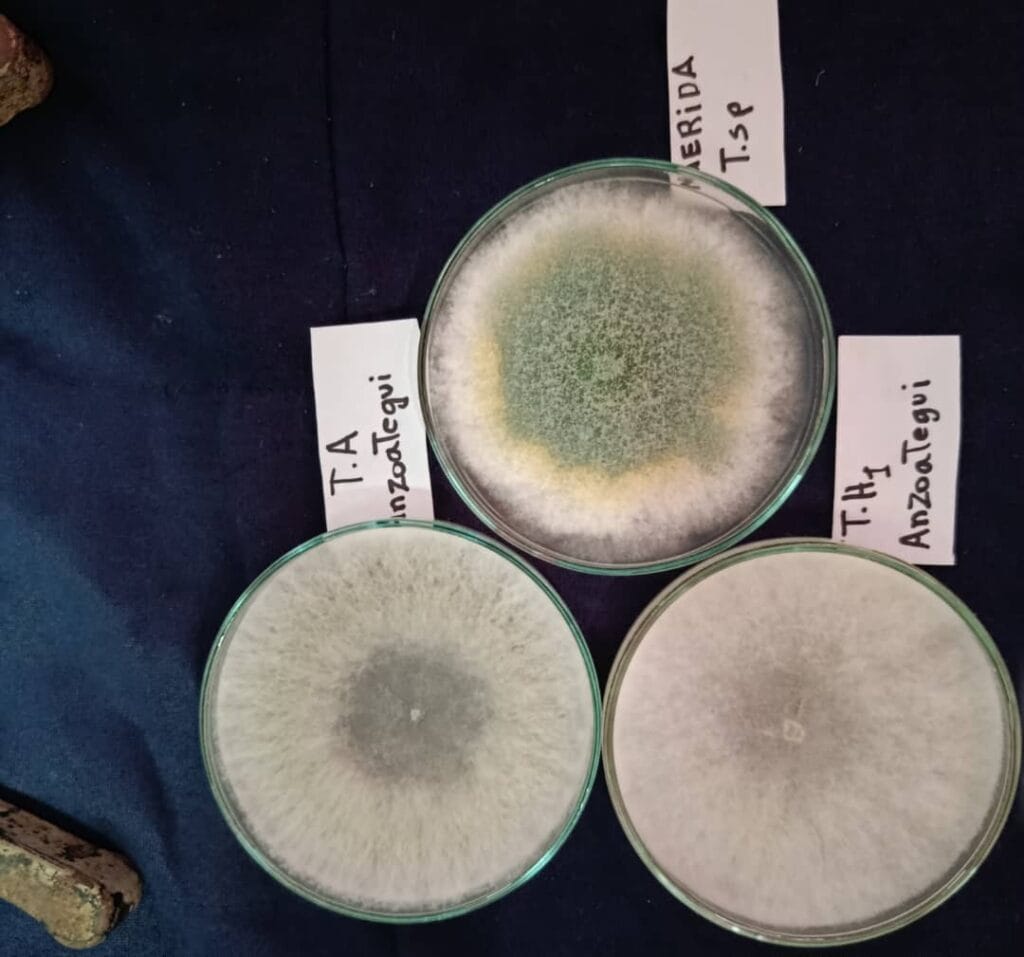
trichoderma

Proyectos en ejecución
El Instituto Nacional de Investigaciones Agrícolas inicia las actividades en tres cuatro proyectos vinculados a la conformación de bancos comunales de semillas, obtención de cultivares de caraota y soya, y al desarrollo de bioinsumos. Estos proyectos cuentan con financiamiento del estado venezolano, a través de organismos nacionales, así como de organizaciones internacionales. A continuación se ofrece una breve descripción de cada uno de ellos.
Incremento de la disponibilidad de cultivares de caraota de alta calidad genética como contribución al proyecto Patria Grande del Sur
Este proyecto tiene como propósito fortalecer la producción de caraota (Phaseolus vulgaris) en Venezuela mediante el desarrollo y disponibilidad de cultivares con alta calidad genética. Su implementación busca mejorar la productividad y sostenibilidad del cultivo en diversas regiones del país, conservar la agrobiodiversidad, impulsar el desarrollo económico local y reforzar la seguridad alimentaria y nutricional. La inversión en esta línea de investigación representa una estrategia clave para atender la creciente demanda nacional de semilla de caraota.


Obtención de cultivares nacionales de Soya (Glycine max (L)) y escalamiento de semilla genética y certificada con prácticas agronómicas sostenibles, como estrategia para la sustitución de importaciones
Iniciativa que se enfoca en el desarrollo de cultivares nacionales de soya, con énfasis en la protección de recursos fitogenéticos mediante bancos de germoplasma in vitro, y en la implementación de prácticas agronómicas sostenibles que impulsen la productividad nacional.


Desarrollo y uso de bioinsumos para una agricultura sostenible en América latina
Es un proyecto que está dirigido al incremento de la disponibilidad de tecnologías basadas en bioinsumos, que contribuyan a mejorar la sostenibilidad de los sistemas productivos agropecuarios en América Latina y el Caribe, a través de la armonización de los protocolos de producción y control de calidad, desarrollo de alternativas biológicas, integración de los bioinsumos en los esquemas de manejo de cultivos estratégicos y promoción del uso eficiente de los mismos.

Producción de semilla en bancos comunales en Venezuela
Proyecto que busca fortalecer la organización de los agricultores con vocación semillerista, a través del fortalecimiento de los bancos comunales de semillas y de las escuelas campesinas, como espacios para la formación, producción y conservación de semillas de cereales y leguminosas, de manera de contribuir con el incremento de la disponibilidad de semilla, requerida para los procesos productivos.








